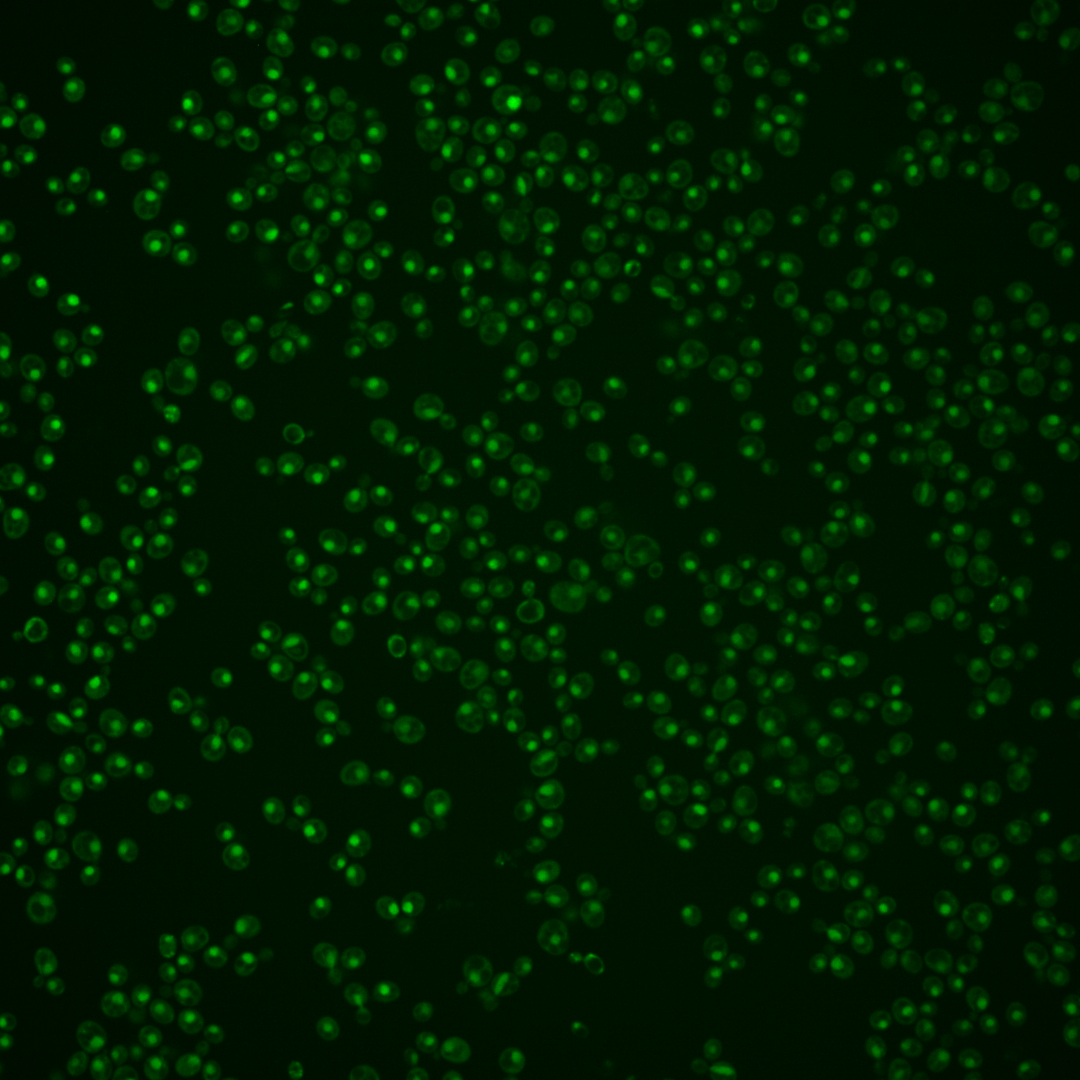
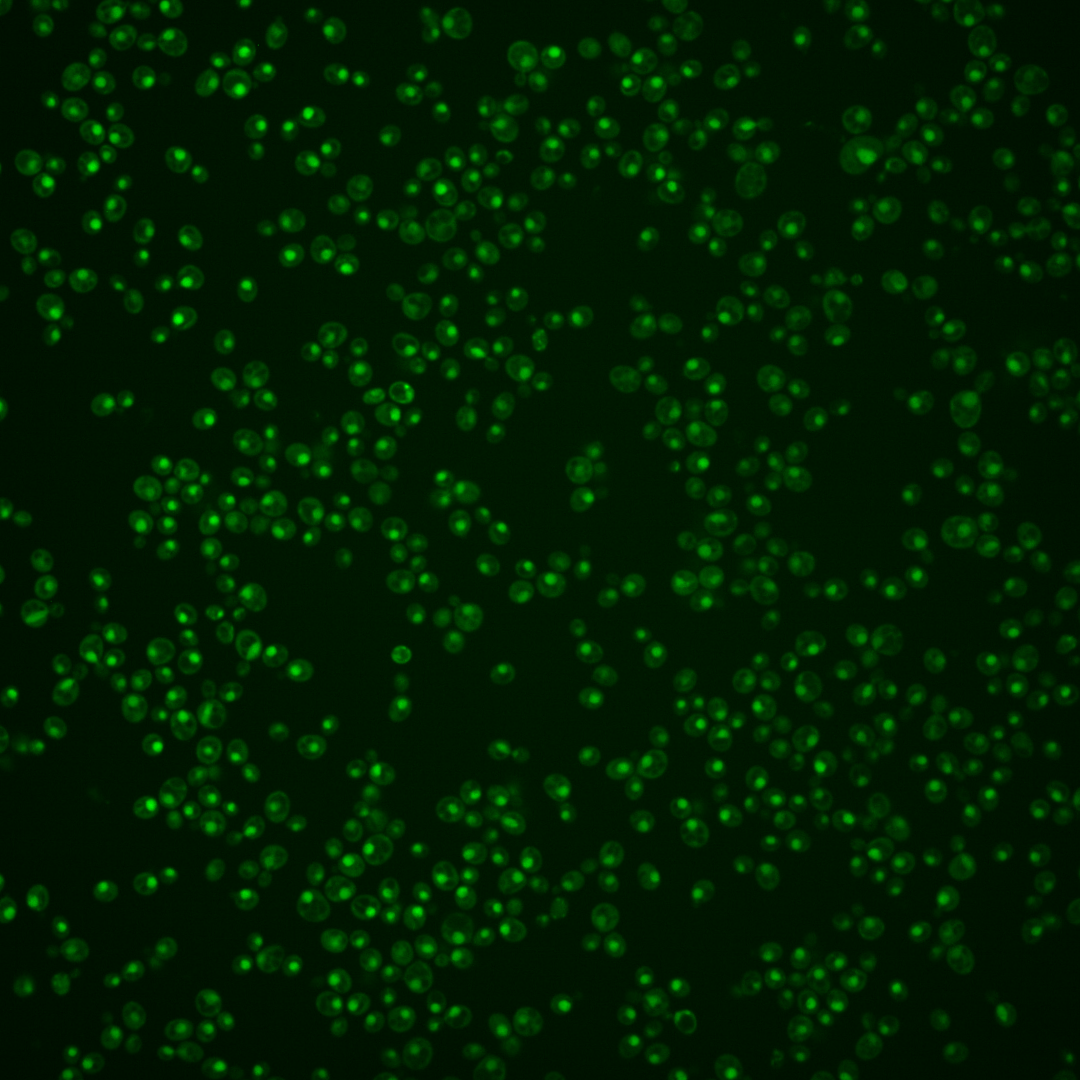
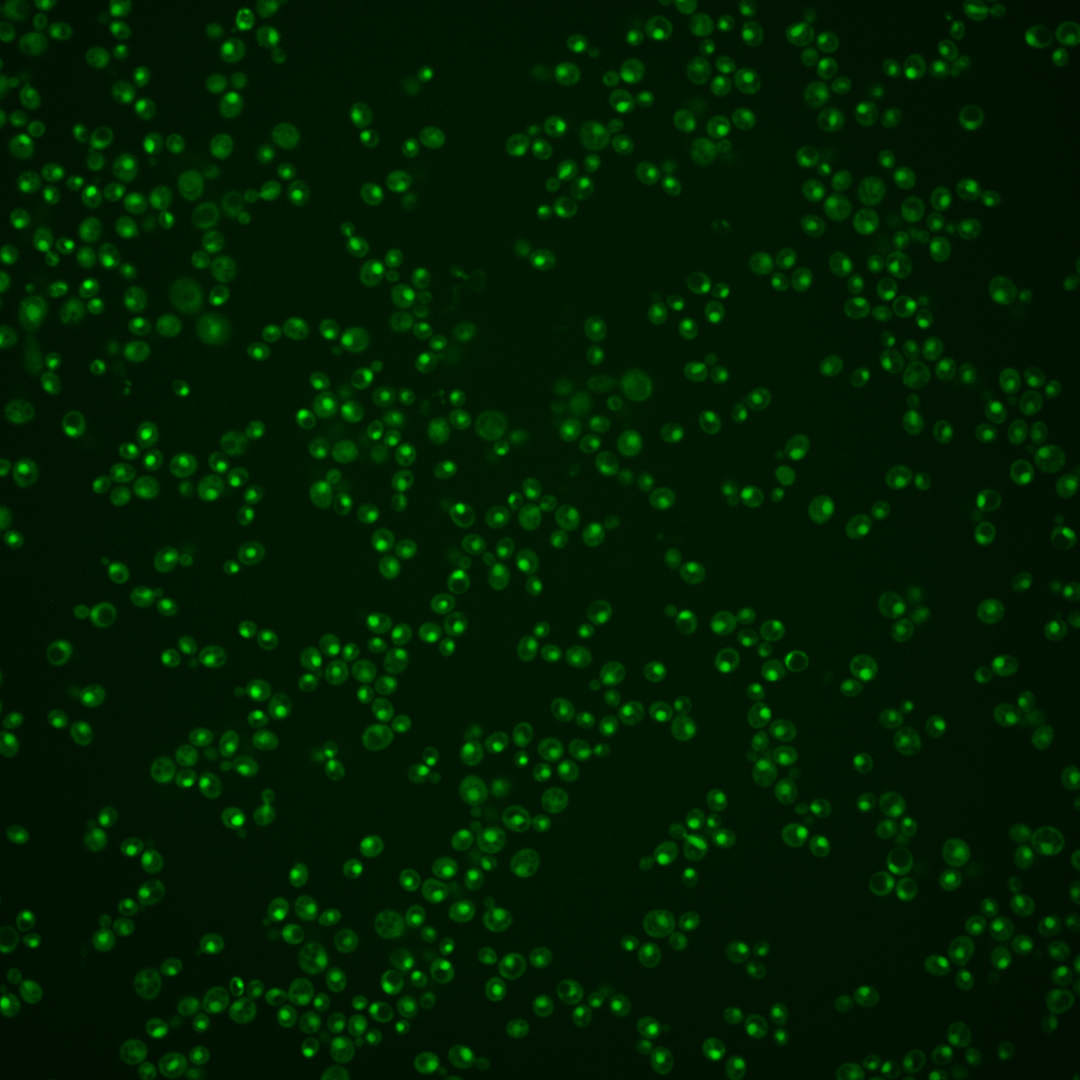
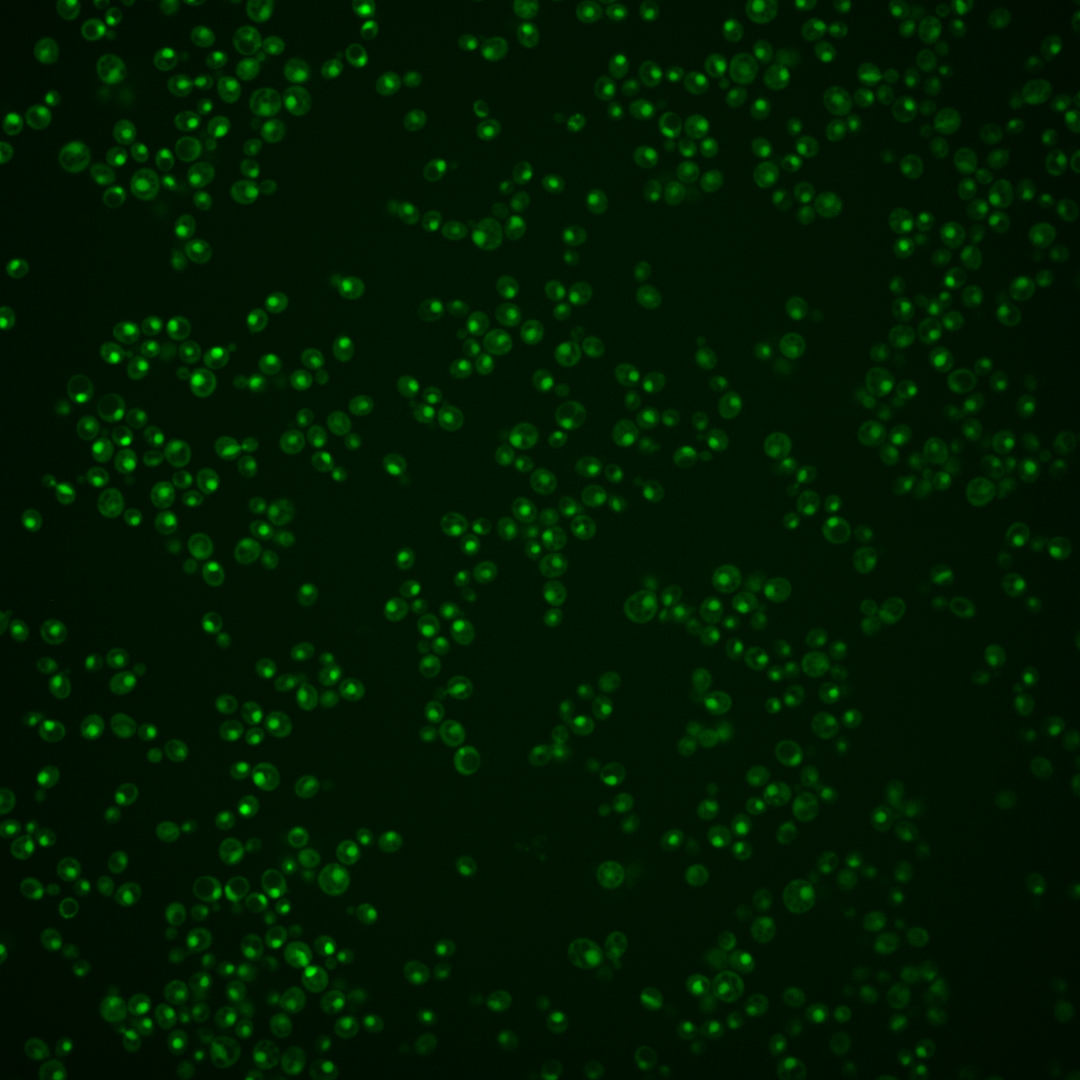

| Standard name | |
|---|---|
| Human Ortholog | |
| Description | Highly conserved negative regulator of RNA polymerase III; involved in tRNA processing and stability; inhibits tRNA degradation via rapid tRNA decay (RTD) pathway; binds N-terminal domain of Rpc160p subunit of Pol III to prevent closed-complex formation; regulated by phosphorylation mediated by TORC1, protein kinase A, Sch9p, casein kinase 2; localizes to cytoplasm during vegetative growth and translocates to nucleus and nucleolus under stress conditions |
Micrographs




















































































Sub-cellular Localization
Yeast GFP Assignment
Protein Abundance
Localization Change
External localization resources
| ensLOC | DeepLoc | |||||||||||||||||||||||
|---|---|---|---|---|---|---|---|---|---|---|---|---|---|---|---|---|---|---|---|---|---|---|---|---|
| Localization | WT1 | WT2 | WT3 | RAP60 | RAP140 | RAP220 | RAP300 | RAP380 | RAP460 | RAP540 | RAP620 | RAP700 | HU80 | HU120 | HU160 | rpd3Δ_1 | rpd3Δ_2 | rpd3Δ_3 | WT1 | WT2 | WT3 | AF100 | AF140 | AF180 |
| Cortical Patches | 0 | 0 | 0 | 0 | 0 | 0 | 0 | 0 | 0 | 0 | 0 | 0 | 0 | 0 | 0 | 1 | 0 | 0 | 0 | 0 | 1 | 0 | 0 | 1 |
| Bud | 0 | 0 | 0 | 0 | 0 | 0 | 3 | 1 | 2 | 2 | 1 | 2 | 0 | 0 | 0 | 0 | 0 | 0 | 7 | 1 | 3 | 4 | 11 | 17 |
| Bud Neck | 0 | 0 | 0 | 0 | 0 | 0 | 0 | 2 | 2 | 0 | 1 | 2 | 0 | 0 | 0 | 0 | 0 | 0 | 0 | 0 | 0 | 0 | 2 | 2 |
| Bud Site | 0 | 0 | 0 | 0 | 1 | 3 | 6 | 12 | 10 | 15 | 20 | 23 | 0 | 0 | 0 | 0 | 0 | 0 | – | – | – | – | – | – |
| Cell Periphery | 0 | 0 | 0 | 0 | 0 | 0 | 0 | 0 | 0 | 0 | 0 | 0 | 0 | 2 | 0 | 0 | 0 | 0 | 0 | 0 | 0 | 0 | 0 | 0 |
| Cytoplasm | 9 | 2 | 6 | 7 | 12 | 10 | 25 | 10 | 7 | 9 | 8 | 13 | 20 | 56 | 78 | 25 | 36 | 26 | 7 | 2 | 2 | 9 | 12 | 11 |
| Endoplasmic Reticulum | 1 | 0 | 1 | 0 | 0 | 0 | 0 | 0 | 0 | 0 | 0 | 0 | 0 | 0 | 0 | 7 | 11 | 8 | 0 | 0 | 1 | 0 | 0 | 2 |
| Endosome | 7 | 0 | 1 | 0 | 0 | 1 | 1 | 1 | 0 | 1 | 0 | 0 | 0 | 2 | 2 | 3 | 2 | 5 | 4 | 0 | 1 | 0 | 9 | 5 |
| Golgi | 0 | 0 | 0 | 0 | 0 | 0 | 0 | 0 | 0 | 0 | 0 | 0 | 0 | 0 | 1 | 0 | 2 | 0 | 2 | 0 | 0 | 0 | 2 | 0 |
| Mitochondria | 24 | 4 | 1 | 4 | 2 | 29 | 66 | 26 | 66 | 80 | 97 | 82 | 0 | 0 | 0 | 3 | 7 | 3 | 6 | 0 | 2 | 0 | 7 | 7 |
| Nucleus | 265 | 103 | 271 | 235 | 336 | 326 | 466 | 456 | 343 | 417 | 504 | 701 | 339 | 444 | 409 | 68 | 81 | 47 | 283 | 108 | 264 | 176 | 441 | 358 |
| Nuclear Periphery | 5 | 0 | 2 | 2 | 2 | 1 | 10 | 11 | 3 | 4 | 3 | 14 | 0 | 0 | 0 | 0 | 0 | 1 | 0 | 0 | 0 | 0 | 0 | 2 |
| Nucleolus | 4 | 0 | 3 | 2 | 4 | 20 | 61 | 62 | 70 | 91 | 138 | 193 | 0 | 4 | 4 | 1 | 0 | 1 | 4 | 1 | 2 | 0 | 10 | 15 |
| Peroxisomes | 0 | 0 | 0 | 0 | 1 | 0 | 1 | 0 | 0 | 0 | 0 | 0 | 0 | 0 | 1 | 0 | 0 | 0 | 0 | 0 | 0 | 0 | 0 | 0 |
| SpindlePole | 0 | 0 | 0 | 0 | 0 | 0 | 1 | 0 | 0 | 1 | 1 | 2 | 1 | 2 | 6 | 0 | 0 | 0 | 5 | 0 | 4 | 4 | 11 | 12 |
| Vac/Vac Membrane | 26 | 18 | 5 | 0 | 2 | 1 | 1 | 1 | 1 | 1 | 2 | 2 | 5 | 2 | 8 | 45 | 70 | 37 | 17 | 9 | 10 | 14 | 43 | 72 |
| Unique Cell Count | 316 | 116 | 286 | 242 | 355 | 363 | 547 | 504 | 419 | 504 | 613 | 858 | 362 | 508 | 504 | 129 | 179 | 106 | 344 | 126 | 298 | 217 | 557 | 513 |
| Labelled Cell Count | 341 | 127 | 290 | 250 | 360 | 391 | 641 | 582 | 504 | 621 | 775 | 1034 | 365 | 512 | 509 | 153 | 209 | 128 | 344 | 126 | 298 | 217 | 557 | 513 |
Yeast GFP Assignment
Protein Abundance
| Screen | WT1 | WT2 | WT3 | RAP60 | RAP140 | RAP220 | RAP300 | RAP380 | RAP460 | RAP540 | RAP620 | RAP700 | HU80 | HU120 | HU160 | rpd3Δ_1 | rpd3Δ_2 | rpd3Δ_3 | AF100 | AF140 | AF180 |
|---|---|---|---|---|---|---|---|---|---|---|---|---|---|---|---|---|---|---|---|---|---|
| Mean Cell GFP Intensity (1e-4) | 5.6 | 6.6 | 6.6 | 6.2 | 6.7 | 5.9 | 5.8 | 5.9 | 5.6 | 5.4 | 5.3 | 5.6 | 7.9 | 7.9 | 7.5 | 8.9 | 8.6 | 9.9 | 7.2 | 7.3 | 7.9 |
| Std Deviation (1e-4) | 0.8 | 1.2 | 1.5 | 1.5 | 1.7 | 1.3 | 1.5 | 1.5 | 1.2 | 1.2 | 1.2 | 1.2 | 1.3 | 1.7 | 1.7 | 1.9 | 2.1 | 16.2 | 1.0 | 1.5 | 1.6 |
| Intensity Change (Log2) | – | – | – | -0.11 | 0.02 | -0.18 | -0.19 | -0.17 | -0.26 | -0.3 | -0.32 | -0.24 | 0.24 | 0.26 | 0.18 | 0.42 | 0.37 | 0.57 | 0.11 | 0.15 | 0.26 |
Localization Change
| Localization | RAP60 | RAP140 | RAP220 | RAP300 | RAP380 | RAP460 | RAP540 | RAP620 | RAP700 | HU80 | HU120 | HU160 | rpd3Δ_1 | rpd3Δ_2 | rpd3Δ_3 |
|---|---|---|---|---|---|---|---|---|---|---|---|---|---|---|---|
| Cortical Patches | 0 | 0 | 0 | 0 | 0 | 0 | 0 | 0 | 0 | 0 | 0 | 0 | 0 | 0 | 0 |
| Bud | 0 | 0 | 0 | 0 | 0 | 0 | 0 | 0 | 0 | 0 | 0 | 0 | 0 | 0 | 0 |
| Bud Neck | 0 | 0 | 0 | 0 | 0 | 0 | 0 | 0 | 0 | 0 | 0 | 0 | 0 | 0 | 0 |
| Bud Site | 0 | 0 | 0 | 0 | 0 | 0 | 2.9 | 3.1 | 2.8 | 0 | 0 | 0 | 0 | 0 | 0 |
| Cell Periphery | 0 | 0 | 0 | 0 | 0 | 0 | 0 | 0 | 0 | 0 | 0 | 0 | 0 | 0 | 0 |
| Cytoplasm | 0.6 | 1.0 | 0.5 | 1.8 | -0.1 | -0.4 | -0.3 | 0 | 0 | 2.2 | 4.5 | 5.9 | 6.2 | 6.6 | 7.2 |
| Endoplasmic Reticulum | 0 | 0 | 0 | 0 | 0 | 0 | 0 | 0 | 0 | 0 | 0 | 0 | 0 | 0 | 0 |
| Endosome | 0 | 0 | 0 | 0 | 0 | 0 | 0 | 0 | 0 | 0 | 0 | 0 | 0 | 0 | 0 |
| Golgi | 0 | 0 | 0 | 0 | 0 | 0 | 0 | 0 | 0 | 0 | 0 | 0 | 0 | 0 | 0 |
| Mitochondria | 0 | 0 | 4.6 | 5.9 | 3.6 | 6.8 | 6.9 | 6.9 | 5.2 | 0 | 0 | 0 | 0 | 0 | 0 |
| Nucleus | 1.3 | -0.1 | -2.3 | -4.1 | -2.1 | -5.0 | -4.8 | -5.1 | -5.3 | -0.6 | -3.3 | -5.3 | -10.2 | -12.1 | -11.3 |
| Nuclear Periphery | 0 | 0 | 0 | 0 | 0 | 0 | 0 | 0 | 0 | 0 | 0 | 0 | 0 | 0 | 0 |
| Nucleolus | 0 | 0 | 3.1 | 5.2 | 5.5 | 6.7 | 7.1 | 8.2 | 8.3 | 0 | 0 | 0 | 0 | 0 | 0 |
| Peroxisomes | 0 | 0 | 0 | 0 | 0 | 0 | 0 | 0 | 0 | 0 | 0 | 0 | 0 | 0 | 0 |
| SpindlePole | 0 | 0 | 0 | 0 | 0 | 0 | 0 | 0 | 0 | 0 | 0 | 0 | 0 | 0 | 0 |
| Vacuole | 0 | 0 | 0 | 0 | 0 | 0 | 0 | 0 | 0 | 0 | 0 | 0 | 9.6 | 10.7 | 9.4 |
External localization resources
Images






























Protein Concentration and Protein Localization Data
| R1 | R2 | R3 | ||||||||||||||||
|---|---|---|---|---|---|---|---|---|---|---|---|---|---|---|---|---|---|---|
| G1 Pre-START | G1 Post-START | S/G2 | Metaphase | Anaphase | Telophase | G1 Pre-START | G1 Post-START | S/G2 | Metaphase | Anaphase | Telophase | G1 Pre-START | G1 Post-START | S/G2 | Metaphase | Anaphase | Telophase | |
| Concentration | 3.5021 | 3.5295 | 3.1633 | 3.0757 | 2.7628 | 3.1076 | 2.3644 | 2.8514 | 2.2194 | 2.296 | 2.2443 | 2.3399 | 2.0357 | 2.192 | 1.6561 | 1.8468 | 1.5036 | 1.4524 |
| Actin | 0.0201 | 0.0002 | 0 | 0 | 0.0001 | 0.0001 | 0.0631 | 0 | 0.0006 | 0.0038 | 0.0001 | 0.0007 | 0.0381 | 0.0001 | 0.0033 | 0.0114 | 0.0183 | 0.0001 |
| Bud | 0.0001 | 0.0001 | 0 | 0 | 0 | 0 | 0.0015 | 0 | 0.0004 | 0.0011 | 0.0001 | 0.0004 | 0.0008 | 0.0001 | 0.0001 | 0.0014 | 0.0001 | 0.0002 |
| Bud Neck | 0.0004 | 0.0005 | 0.0001 | 0.0001 | 0.0003 | 0.0024 | 0.0107 | 0.0001 | 0.0001 | 0.0005 | 0.0006 | 0.0015 | 0.0078 | 0.0001 | 0.0018 | 0.0023 | 0.0007 | 0.0012 |
| Bud Periphery | 0.0001 | 0 | 0 | 0 | 0 | 0.0001 | 0.0024 | 0 | 0.0004 | 0.0036 | 0.0001 | 0.0006 | 0.0019 | 0.0001 | 0.0001 | 0.0014 | 0.0002 | 0.0001 |
| Bud Site | 0.0001 | 0.0007 | 0.0001 | 0 | 0.0001 | 0.0001 | 0.0257 | 0.0001 | 0.0016 | 0.0011 | 0.0001 | 0.0011 | 0.0035 | 0.0001 | 0.0055 | 0.0141 | 0.0002 | 0.0004 |
| Cell Periphery | 0 | 0 | 0 | 0 | 0 | 0 | 0.0011 | 0 | 0 | 0.0002 | 0 | 0.0001 | 0.0004 | 0 | 0.0001 | 0.0003 | 0 | 0 |
| Cytoplasm | 0.0049 | 0.0949 | 0.0344 | 0.0259 | 0.0247 | 0.012 | 0.007 | 0.0359 | 0.0122 | 0.0125 | 0.0027 | 0.0085 | 0.0026 | 0.0142 | 0.0052 | 0.002 | 0.0033 | 0.0051 |
| Cytoplasmic Foci | 0.0008 | 0.0009 | 0.0002 | 0.0001 | 0.0003 | 0.0003 | 0.0451 | 0.0001 | 0.0026 | 0.0007 | 0 | 0.0023 | 0.0273 | 0.0001 | 0.0013 | 0.0032 | 0.0033 | 0.0026 |
| Eisosomes | 0.0002 | 0 | 0 | 0 | 0 | 0 | 0.0006 | 0 | 0 | 0.0001 | 0 | 0 | 0.0003 | 0 | 0 | 0.0001 | 0.0001 | 0 |
| Endoplasmic Reticulum | 0.0003 | 0.0007 | 0.001 | 0.0004 | 0.0016 | 0.0003 | 0.0086 | 0.0005 | 0.0002 | 0.0007 | 0.0003 | 0.0005 | 0.0041 | 0.0004 | 0.0002 | 0.0011 | 0.0005 | 0.0001 |
| Endosome | 0.0012 | 0.0004 | 0.0002 | 0.0005 | 0.0019 | 0.0004 | 0.0664 | 0.0002 | 0.0029 | 0.0106 | 0.0001 | 0.0069 | 0.0218 | 0.0002 | 0.0011 | 0.0082 | 0.0049 | 0.0021 |
| Golgi | 0.0011 | 0 | 0 | 0 | 0 | 0 | 0.0186 | 0 | 0.0023 | 0.0052 | 0 | 0.0061 | 0.0105 | 0 | 0.0013 | 0.0044 | 0.0074 | 0.0006 |
| Lipid Particles | 0.0008 | 0 | 0 | 0 | 0.0001 | 0 | 0.0199 | 0 | 0.0027 | 0.0022 | 0 | 0.0115 | 0.0167 | 0 | 0.0007 | 0.0075 | 0.0129 | 0.0003 |
| Mitochondria | 0.0003 | 0.0002 | 0.0001 | 0.0003 | 0.0003 | 0.0001 | 0.0127 | 0.0002 | 0.0026 | 0.0073 | 0.0006 | 0.0043 | 0.013 | 0.001 | 0.0015 | 0.0073 | 0.0013 | 0.0006 |
| None | 0.0166 | 0.0165 | 0.0124 | 0.0017 | 0.0149 | 0.0068 | 0.0041 | 0.0021 | 0.0007 | 0.0003 | 0.0002 | 0.0003 | 0.0019 | 0.0001 | 0.0007 | 0.0003 | 0.0004 | 0.0001 |
| Nuclear Periphery | 0.0027 | 0.0042 | 0.0049 | 0.0032 | 0.0291 | 0.0033 | 0.0204 | 0.0043 | 0.0045 | 0.0042 | 0.0099 | 0.0091 | 0.0188 | 0.0048 | 0.0013 | 0.0033 | 0.0029 | 0.0012 |
| Nucleolus | 0.0048 | 0.004 | 0.0033 | 0.0018 | 0.0069 | 0.0103 | 0.0113 | 0.0026 | 0.0025 | 0.0025 | 0.0091 | 0.0071 | 0.0046 | 0.0031 | 0.0025 | 0.0033 | 0.0086 | 0.0065 |
| Nucleus | 0.929 | 0.8644 | 0.9389 | 0.9634 | 0.905 | 0.9504 | 0.6142 | 0.9504 | 0.9557 | 0.9355 | 0.974 | 0.9321 | 0.7953 | 0.9675 | 0.9705 | 0.923 | 0.929 | 0.976 |
| Peroxisomes | 0.0004 | 0 | 0 | 0 | 0 | 0 | 0.0239 | 0 | 0.0044 | 0.0004 | 0 | 0.0016 | 0.0138 | 0 | 0.0002 | 0.0017 | 0.0034 | 0.0008 |
| Punctate Nuclear | 0.0159 | 0.0117 | 0.0038 | 0.0022 | 0.0135 | 0.0128 | 0.0114 | 0.0028 | 0.0029 | 0.0022 | 0.001 | 0.0033 | 0.0107 | 0.0066 | 0.0021 | 0.0015 | 0.0021 | 0.0017 |
| Vacuole | 0.0001 | 0.0005 | 0.0003 | 0.0003 | 0.0007 | 0.0004 | 0.0209 | 0.0003 | 0.0005 | 0.0033 | 0.0006 | 0.0012 | 0.0041 | 0.0007 | 0.0002 | 0.0015 | 0.0002 | 0.0003 |
| Vacuole Periphery | 0.0001 | 0.0001 | 0.0001 | 0.0002 | 0.0004 | 0.0001 | 0.0105 | 0.0001 | 0.0002 | 0.0021 | 0.0003 | 0.0007 | 0.0022 | 0.0006 | 0.0001 | 0.0006 | 0.0002 | 0.0001 |
Sequencing Data
| R1 | R2 | |||||||||
|---|---|---|---|---|---|---|---|---|---|---|
| G1 Post-START | S/G2 | Metaphase | Anaphase | Telophase | G1 Post-START | S/G2 | Metaphase | Anaphase | Telophase | |
| Gene Expression | 19.0402 | 23.2479 | 12.9382 | 18.3993 | 19.2675 | 14.8524 | 17.6295 | 23.5141 | 20.4077 | 23.702 |
| Translational Efficiency | 0.9579 | 0.7359 | 1.1812 | 0.8098 | 0.8919 | 1.6515 | 1.3839 | 0.9421 | 1.0256 | 1.0396 |
Hit Data
| Dataset | Hit |
|---|---|
| Protein Concentration | ✘ |
| Protein Localization | ✘ |
| Gene Expression | ✘ |
| Translational Efficiency | ✘ |
Endocytosis
| Temp | Actin Patch (Sac6-tdTomato) | Cortical Patch (Sla1-GFP) | Late Endosome (Snf7-GFP) | Vacuole (Vph1-GFP) |
|---|---|---|---|---|
| 37℃ | ||||
| RT |
Cell Cycle Omics
CYCLoPs (Maf1-GFP)
| Gene / Allele | Actin Patch (Sac6-tdTomato) | Cortical Patch (Sla1-GFP) | Late Endosome (Snf7-GFP) | Vacuole (Sac6-tdTomato) |
|---|
| Gene | Images |
|---|
| Gene | Images |
|---|
Images are not yet available
Images are not yet available